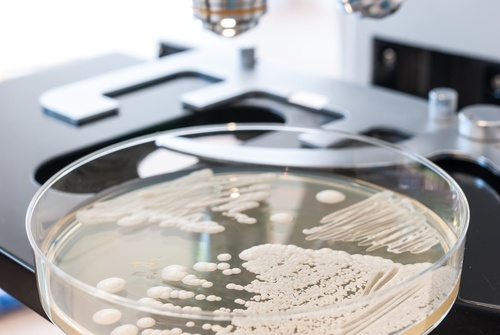
Teste caseiro para detectar cândida

Teste caseiro para detectar a cândida no corpo e como eliminá-la naturalmente


Revisado e aprovado por a médica Maricela Jiménez López
A cândida é um tipo de fungo ou levedura presente em todos os corpos saudáveis em uma quantidade equilibrada. Ainda que a maioria das pessoas a associem com uma infecção, o certo é que ela cumpre um papel importante na digestão e absorção dos nutrientes. Aprenda aqui a como detectar a cândida.
No entanto, quando se perde o equilíbrio da cândida no corpo, ela pode liberar toxinas na corrente sanguínea e provocar uma série de sintomas que podem afetar a saúde desde diferentes aspectos.
Com frequência, os problemas da cândida ocorrem quando se reduzem seus níveis normais no organismo como consequência do consumo de antibióticos, o estresse e uma dieta alta em carboidratos refinados e açúcares.
Quais são os sintomas que surgem e como detectar a cândida?
O crescimento excessivo ou a redução da cândida podem causar um desequilíbrio das bactérias que contribuem para várias funções do corpo. Como consequência disso, a pessoa pode ter os seguintes sintomas:
- Alergias a alguns alimentos
- Irritabilidade
- Infecções vaginais por fungos
- Desejo de ingerir açúcar
- Falta de concentração
- Inchaço ou prisão de ventre
- Fadiga
- Dores de cabeça
- Camada branca grossa na língua
- Depressão
- Erupções na pele como eczemas
- Acne
- Transtornos imunológicos
Descubra: Em que ponto da depressão você deve procurar ajuda?
Teste caseiro para detectar a cândida
O teste para detectar a cândida existe há algum tempo, mas a sua origem é desconhecida. Apesar disso, acredita-se que seja muito confiável.
- Quando acordar pela manhã, antes de ingerir qualquer coisa, junte um pouco de saliva e cuspa-a em um copo de vidro com água.
- Deixe passar entre 1 e 30 minutos e observe as mudanças que vão se apresentando no copo.
- Se houver cadeias de saliva que abaixam, se a água se tornou turva, ou se a saliva afundou, é possível que exista um problema de cândida.
- Se a saliva flutua normalmente, isso quer dizer que a cândida está equilibrada.
Como funciona este teste?
A cândida começa no cólon, mas com o tempo, conforme a levedura se multiplica, começa a migrar para o sistema digestivo, chegando ao intestino delgado, logo ao estômago, esôfago e dentro da boca.
Se ela se desenvolver em excesso e chegar até a boca, é muito provável que exista uma camada branca na língua, que inclusive pode cobrir o interior das bochechas.
Ao cuspi-la em um copo de água, ela simplesmente afunda porque é mais pesada do que a água.
Como eliminar a cândida naturalmente?
Evite o consumo de açúcar e de carboidratos refinados

Este tipo de alimento piora a cândida e propaga seu crescimento no corpo, por isso é melhor evitá-los ao máximo até que nos sintamos melhores.
Se a ansiedade pelo doce atacar, opte por consumir frutas de baixo índice glicêmico.
Aumente o consumo de alimentos antifúngicos
Os antibióticos naturais são uma das melhores opções para combater os fungos ou leveduras sem correr o risco de sofrer efeitos colaterais.
Entre os alimentos recomendados nesta situação, encontram-se:
- O alho e a cebola
- O óleo de coco
- O vinagre de maçã
- A camomila
- A lavanda
- O gengibre
- O limão
- A pimenta-caiena
Recomendamos a leitura: Mil e uma utilidades do óleo de coco
Tome suplementos probióticos

Os probióticos contêm bactérias boas que reduzem o impacto causado pelo desequilíbrio da cândida.
Entre os probióticos que você pode consumir se destacam:
- O iogurte natural com culturas ativas
- Alimentos fermentados
- Suplementos em cápsulas, pílulas ou em forma de pó
- Reduzir o estresse
Os níveis elevados de estresse têm um efeito negativo nos níveis de açúcar no sangue, o que por sua vez contribui para o crescimento da cândida.
Se o teste der positivo, talvez você deva analisar se sofre de estresse e fazer atividades para combatê-lo.
Ajude seu sistema de desintoxicação

A limpeza do organismo é muito importante para eliminar o excesso de cândida que morreu mas continua acumulada no corpo.
Para eliminar a levedura, é muito importante iniciar um plano de desintoxicação que inclua alimentos como:
- O coentro
- A salsinha
- Verduras de folhas verdes
- A beterraba
- O dente-de-leão
- Algas e vegetais marinhos
- As alcachofras
- A cúrcuma
- As maçãs
Se além de tê-la confirmado no teste caseiro a cândida estiver se manifestando através de outros sintomas, é muito importante consultar um médico para combatê-la de forma adequada.
Todas as fontes citadas foram minuciosamente revisadas por nossa equipe para garantir sua qualidade, confiabilidade, atualidade e validade. A bibliografia deste artigo foi considerada confiável e precisa academicamente ou cientificamente.
Spampinato, C., & Leonardi, D. (2013). Candida infections, causes, targets, and resistance mechanisms: traditional and alternative antifungal agents. BioMed Research International, 2013, 204237. https://doi.org/10.1155/2013/204237
Singh, A., Verma, R., Murari, A., & Agrawal, A. (2014). Oral candidiasis: An overview. Journal of Oral and Maxillofacial Pathology : JOMFP, 18(Suppl 1), S81-5. https://doi.org/10.4103/0973-029X.141325
Este texto é fornecido apenas para fins informativos e não substitui a consulta com um profissional. Em caso de dúvida, consulte o seu especialista.







